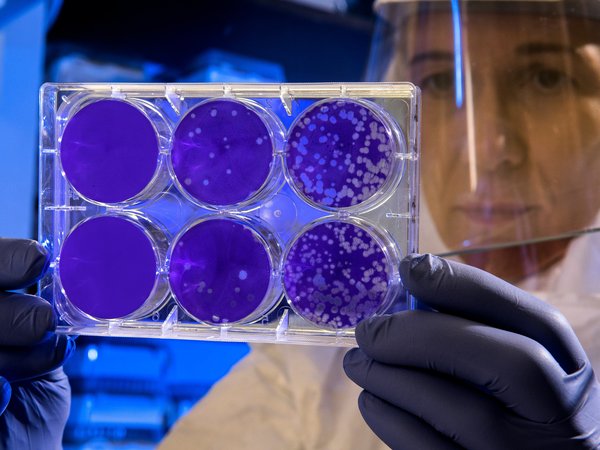

Какие еще эпидемии были? Как люди пережили Эболу, SARS, MERS и вирус Зика

Человечество переживало не одну эпидемию, в том числе коронавирусную — тяжелые респираторные синдромы, Эбола, лихорадка Зика. Некоторые из них пришли к нам также от летучих мышей, какие-то — тоже из Китая.
Атипичная пневмония SARS
Что это? Тяжелый респираторный синдром, возбудитель — коронавирус SARS (severe acute respiratory syndrome-related coronavirus, SARS-CoV). Ученые точно не знают о происхождении коронавируса SARS, но, вероятно, он жил в организме летучих мышей и передался животному — предположительно, циветте, а затем попал к человеку. Заболевание проявлялся чаще всего во вторую неделю после инфицирования. Вирус передавался от человеку к человеку в больницах при отсутствии надлежащих мер инфекционного контроля. Когда нужные меры были внедрены, вирус удалось победить.
Когда появилась? В ноябре 2002 года.
Где? В китайской провинции Гуандун. За два месяца заболевание перекинулось на Гонконг и Вьетнам, а затем распространилось на 26 стран мира, в том числе Сингапур, Вьетнам, Канаду, а также в Тайбэй.
 Мигранты покидают город Гуанчжоу в Китае, май 2003 / The Epoch Times
Мигранты покидают город Гуанчжоу в Китае, май 2003 / The Epoch Times Симптомы похожи на грипп —лихорадка, утомляемость, головная боль, высокая температура, озноб, диарея. У SARS нет специфических симптомов, по которым его можно было бы сразу определить. Во вторую неделю болезни появляется кашель и становится трудно дышать. Тяжелые симптомы развиваются быстро и требуют интенсивной терапии.
Сколько человек заразились? 8437 человек, скончались 813. Уровень летальности — около 9 %, среди пациентов старше 50 лет — 50%.
Когда закончилась? Последний случай заболевания зарегистрирован в июне 2003 года. После этого случайно заразились три человека из-за нарушений техники безопасности в лабораториях в Сингапуре и Тайбэе. Еще одному человеку на юге Китая вирус передался, вероятно, от животного, но точные обстоятельства неизвестны.
Есть ли вакцина? Нет. Вакцина на стадии разработки.
Ближневосточный респираторный синдром MERS
Что это? БВРС — вирусное респираторное заболевание, его вызывает коронавирус нового типа MERS-COV (Middle East respiratory syndrome coronavirus).
Когда появился? В 2012 году. Ученые выяснили, что БВРС попал в организм людей из-за контакта с инфицированными одногорбыми верблюдами. Происхождение вируса до конца неизвестно, но ученые полагают, что вирус попал в организм верблюдов от летучих мышей в отдаленном прошлом.
Где? Впервые MERS диагностировали в Саудовской Аравии, именно там заразились 80% всех пациентов. Но БВРС-КоВ всё же распространился еще на 26 стран: Алжир, Австрию, Бахрейн, Китай, Египет, Францию, Германию, Грецию, Исламскую Республику Иран, Италию, Иорданию, Кувейт, Ливан, Малайзию, Нидерланды, Оман, Филиппины, Катар, Республику Корея, Королевство Таиланд, Тунис, Турцию, Объединенные Арабские Эмираты, Соединенное Королевство, Соединенные Штаты Америки и Йемен.
 Обследование верблюда во время вспышки MERS, март 2009 года / Awadh Mohammed Ba Saleh
Обследование верблюда во время вспышки MERS, март 2009 года / Awadh Mohammed Ba Saleh Симптомы: высокая температура, кашель, одышка, диарея. Пневмония развивается часто, но не всегда. У некоторых людей БВРС проходил без симптомов — заболевание зарегистрировали, когда проверяли тех, с кем контактировали заболевшие. При тяжелом течении болезни нужна механическая вентиляция легких, так как возможна остановка дыхания. БВРС тяжелее переносили пожилые люди, люди с ослабленным иммунитетом и те, кто у кого были онкологические заболевания, болезни легких и диабет. От человека к человеку вирус передавался непросто — для этого нужен тесный контакт, например, когда пациенту оказывают медицинскую помощь без средств защиты.
Сколько человек заразились? Умерли примерно 34% заболевших. По состоянию на январь 2020 года, по данным ВОЗ, заболели 2519 человек, умерли 866.
Когда закончился? Последний случай заболевания БВРС зарегистрировали в январе 2020 года: заболела медсестра в Саудовской Аравии.
Есть ли вакцина? Ни вакцины, ни специфического лечения от БВРС-КоВ не существует — их только разрабатывают. Лечение заключается в назначении поддерживающей терапии. Для профилактики заболевания рекомендуют мыть руки после прикосновения к верблюдам, а также кипятить или пастеризовать верблюжье молоко и качественно термически обрабатывать мясо.
Лихорадка Эбола
Что это? Болезнь, вызванная вирусом Эбола (БВВЭ) (сначала ее называли геморрагической лихорадкой), тяжелая и часто смертельная. По данным ВОЗ, естественный носитель вируса Эболы — летучие мыши семейства Pteropodidae. А в организм человека вирус попал через контакт с кровью и выделениями инфицированных животных — обезьян, антилоп, дикобразов, когда их находили мертвыми или больными во влажных лесах. После этого вирус начал передаваться от человека к человеку, но не воздушно-капельным путем, как в случае с COVID-19, а при тесном контакте с кровью и физиологическими жидкостями заболевшего. Вирусом Эболы заражаются, если поврежденная кожа или слизистая оболочка контактировала с кровью или выделениями больного или с предметами, на которых они были.
Когда появилась? О лихорадке Эболы стало известно в 1976 году, когда одновременно начались вспышки в городе Нзаре в нынешнем Южном Судане (тогда — Судан) и в маленькой деревне Ямбуку в Конго (тогда — Республика Заир). Вирус обнаружили рядом с рекой Эболой в Конго — отсюда и название.
Следующая вспышка Эболы произошла в Западной Африке в 2014–2016 годах — она стала самой крупной из всех. Вирус появился в Гвинее, затем перекинулся через сухопутные границы в Сьерру-Леоне и Либерию.
Лихорадка снова появилась в 2018 году в восточных районах Конго, эпидемия длится до сих пор. ВОЗ указывает, что она «носит чрезвычайно сложный характер, в том числе потому, что принятие ответных мер в области общественного здравоохранения всерьез затрудняется небезопасной обстановкой».
Где? Западная Африка: Конго, Южный Судан, Сьерра-Леоне, Либерия, Гвинея, Габон, Руанда, Бурунди, Мали, Нигерия, Уганда, по одному случаю в Испании, Италии, Великобритании, в США — четыре.
 Работники ВОЗ во время вспышки Эбола, Нигерия, август 2014
Работники ВОЗ во время вспышки Эбола, Нигерия, август 2014 Симптомы: Инкубационный период длится от 2 до 21 дня. Инфицированный человек не может заразить других до того, как у него появятся симптомы: лихорадка, слабость, мышечные боли, головная боль, боль в горле. На следующем этапе болезни появляется рвота, диарея, сыпь, нарушение функции почек и печени, в некоторых случаях выделяется кровь из десен и с калом.
Сколько человек заболели? Показатель летальности — от 25 до 90 %, средний коэффициент — около 50 %. Во время вспышки в 1976–1979 годах в Южном Судане и Конго заболели 637 человек, умерли 454. По данным ВОЗ, к 2018 году лихорадкой Эбола заболели 31 161 человек, умерли 12 999.
Когда закончилась? Вспышка в Конго длится до сих пор.
Есть ли вакцина? В октябре 2019 года Европейское агентство по лекарственным средствам (ЕМА) — эта организация дает научную оценку лекарственных средств, разрабатываемых фармацевтическими компаниями, — рекомендовала выдать лицензию вакцине rVSV-ZEBOV-GP, ее эффективность удалось доказать. Лицензированная вакцина станет доступна в середине 2020 года. До этого вакцину используют по экспериментальному протоколу — его называют использованием из соображений гуманности. Прививки получили уже 236 тыс. человек в Конго, Уганде, Южном Судане, Руанде и Бурунди.
Лихорадка Зика
Что это? Вирус Зика передается при укусах комаров рода Aedes в тропиках и субтропиках. Эти насекомые обычно активны ранним утром и ранним вечером. Между людьми вирус Зика передается половым путем, при переливании крови, пересадке органов от матери к плоду.
Когда появилась? Ученые впервые обнаружили вирус Зика у обезьян в Уганде в 1947 году. У людей его нашли в 1952 году в Уганде и Танзании. Отдельные случаи заболевания были еще в 1960–1980 годах в Африке и Азии.
Первая вспышка инфицирования вирусом Зика произошла на острове Яп в Микронезии в 2007 году, затем — в Полинезии в 2013 году и других странах Тихоокеанского региона. В марте 2015 года вирус пришел в Бразилию.
В октябре 2015 года ученые выяснили, что вирус Зика вызывает микроцефалию у детей, чьи матери были инфицированы во время беременности. Поэтому власти Бразилии попросили женщин отложить планирование беременности до тех пор, пока вспышка не угаснет. Вспышки вируса Зика также происходили в Америке, Африке и других регионах.
Где? Африка, Южная Америка, Азия, Тихоокеанский регион — всего 86 стран, в том числе и Россия.
 Мэрия города Вотупоранга в Бразилии обеззараживает частные дома
Мэрия города Вотупоранга в Бразилии обеззараживает частные дома Симптомы: повышенная температура, сыпь, конъюнктивит, боли в мышцах, головная боль. Но у большинства людей, инфицированных вирусом Зика, не появляется никаких симптомов. Главное осложнение — патологии плода и развитие микроцефалии — значительного уменьшения головы плода. У людей старшего возраста может развиться синдром Гийена-Барре, при котором иммунная система поражает собственные периферические нервы, но большинство людей выздоравливают.
Сколько человек заболели? Лихорадка Зика не смертельна. Из-за того, что у большинства зараженных нет симптомов, нет и полных данных о количестве инфицированных ею людей. Тем не менее, по состоянию на конец 2016 года, в Бразилии зарегистрировали 1,5 млн случаев заражения вирусом Зика.
Как пишет The New York Times, с октября 2015 года по конец января 2016 года 4182 ребенка родились с микроцефалией, ее появление связывают с распространением вируса. С 2010 по 2014 с микроцефалией рождались около 160 детей в год.
В Сальвадоре врачи подтвердили более 7 тыс. случаев заражения, в Колумбии — 25 645, в Гондурасе — 3649, в Венесуэле — 4700, в США — 51. В остальных странах случаи лихорадки Зика были единичными.
Когда закончилась? Вспышка лихорадки закончилась в 2016 году, но случаи заражения происходят до сих пор.
Есть ли вакцина? Вакцины в процессе разработки. ВОЗ также занимается сокращением популяции комаров Aedes.
Смотрите также: Максим Руссо Коронавирус: опыт Южной Кореи Максим Руссо От кого коронавирус? Максим Руссо Бактерия против вируса Зика